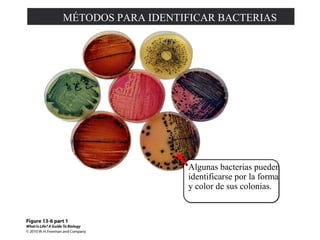
MÉTODOS PARA IDENTIFICAR BACTERIAS 
Algunas bacterias pueden 
identificarse por la forma 
y color de sus colonias.

Este documento trata sobre la evolución y diversidad de los microbios. Explica que los microbios vienen en una variedad de tamaños y formas, y pueden vivir en casi cualquier ambiente. Describe las estructuras y métodos de reproducción de las bacterias, así como su clasificación en dominios. También cubre la diversidad metabólica y los métodos de intercambio genético entre bacterias.